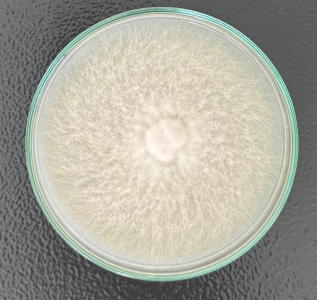
Nghiên cứu thành công giai đoạn 2 giống nấm hương (Lentinula edodes) 2 1
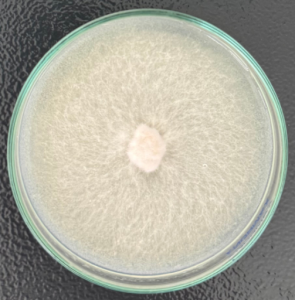
Nghiên cứu thành công giai đoạn 2 giống nấm hương (Lentinula edodes) 3 2

“Giai đoạn 2 của việc nghiên cứu nấm hương (Lentinula edodes), các mẫu meo nấm đã phát triển tương đối tốt trong điều kiện phòng thí nghiệm tại Viện nghiên cứu Sinh học Ứng dụng Trường Đại học Quang Trung. Điều này, chứng minh bước đầu quá trình nghiên cứu giống nấm này có khả năng thích nghi cao.”, ThS. Nguyễn Văn Trung – Đại diện nhóm nghiên cứu cho biết.
Viện Nghiên cứu Sinh học Ứng dụng phối hợp cùng Công ty TNHH Nikko Kinoko no Mori triển khai chương trình sản xuất meo và phôi nấm hương (Lentinula edodes) – loài nấm có giá trị dinh dưỡng, dược liệu cao. Đây là một giống nấm mang lại lợi nhuận kinh tế khá cao. Tại Nhật Bản, nấm hương là một trong những giống nấm mang lại lợi nhuận kinh tế đáng kể cho người dân nhờ giá trị thương phẩm và khả năng thích ứng với nhiều điều kiện khí hậu khác nhau. Trong quá trình khảo sát thực địa tại các khu vực tỉnh Gia Lai, Công ty TNHH Nikko Kinoko no Mori đã có nhận định ban đầu về khả năng thích nghi của giống nấm này ở một số vùng có điều kiện sinh thái tương đồng với các vùng trồng nấm tại Nhật Bản. Từ kết quả này, Công ty TNHH Nikko Kinoko no Mori đã phối hợp cùng Viện Nghiên cứu SHUD nghiên cứu sâu và tiến hành nhân giống, đánh giá hiệu suất sinh trưởng của nấm hương trong điều kiện tại Việt Nam.

Từ tháng 5/2025, chuyên gia của Công ty TNHH Nikko Kinoko no Mori cùng với nhóm nghiên cứu của Viện Nghiên cứu SHUD đã có các buổi làm việc và thống nhất quy trình nghiên cứu để tạo ra meo giống. Giai đoạn đầu, nhóm nghiên cứu đã tiến hành nuôi cấy thử nghiệm giống nấm trên các đĩa petri có chứa môi trường PDA (Potato Dextrose Agar). Sau 21 ngày nuôi cấy, các mẫu đã phát triển hệ sợi tơ trắng, khỏe mạnh, lan tỏa đều trên môi trường và cho thấy tốc độ sinh trưởng nhanh, ổn định.
![]() |
![]() |
Giống nấm hương (Lentinula edodes) sau 21 ngày nuôi cấy
Kawaue Kazumasa – Giám đốc kỹ thuật của Công ty TNHH Nikko Kinoko no Mori cho biết: “Với tốc độ phát triển hệ sợi của các mẫu nghiên cứu, chúng tôi tin tưởng giống nấm hương này sẽ có tiềm năng thích nghi và sinh trưởng tốt tại khu vực miền Trung – Tây Nguyên. Đây là tín hiệu rất tích cực cho giai đoạn tiếp theo của dự án”
Qua quá trình thử nghiệm, meo giống nấm hương (Lentinula edodes) cho thấy sự phát triển ổn định và đồng đều trên giá thể hạt lúa, thể hiện khả năng thích nghi tốt với nguồn nguyên liệu trong nước. Đây được xem là tín hiệu tích cực khi hạt lúa là nguyên liệu sẵn có, giá thành thấp, dễ xử lý, góp phần giảm đáng kể chi phí sản xuất so với việc nhập khẩu meo giống từ nước ngoài.
Thạc sĩ Nguyễn Văn Trung thông tin: “Các mẫu meo nấm trên giá thể lúa tại phòng thí nghiệm của Viện Nghiên cứu SHUD đã phát triển gần như hoàn chỉnh. Sợi nấm lan mạnh, trắng mịn và bền, cho thấy nguồn nguyên liệu trong nước hoàn toàn đáp ứng yêu cầu kỹ thuật của giống nấm hương.”
![]() |
![]() |
Meo giống nấm hương (Lentinula edodes) phát triển trên giá thể lúa
Trong giai đoạn tiếp theo, nhóm nghiên cứu sẽ tiến hành chuyển meo sang phôi thử nghiệm, sử dụng công thức giá thể gồm mùn cưa cây cao su, cám gạo, cám lúa mì và vôi tôi. Mục tiêu nhằm đánh giá khả năng hình thành quả thể và năng suất thu hoạch. Thí nghiệm này sẽ được triển khai song song tại phòng thí nghiệm của Viện Nghiên cứu SHUD và khu nhà lưới thực nghiệm của Trường Đại học Quang Trung.
Kết quả thu được từ giai đoạn này sẽ là cơ sở quan trọng để đánh giá khả năng thương mại hóa giống nấm hương tại Việt Nam, góp phần chủ động nguồn giống chất lượng cao, giảm phụ thuộc vào nhập khẩu. Đồng thời, mở ra hướng liên kết – chuyển giao công nghệ, mở rộng mô hình nuôi trồng nấm theo công nghệ Nhật Bản, phù hợp với điều kiện sản xuất tại địa phương.
Hiện nay, Viện Nghiên cứu SHUD là một trong những đơn vị có năng lực chuyên môn vững vàng trong lĩnh vực sinh học ứng dụng và công nghệ vi sinh vật. Viện sở hữu hệ thống phòng thí nghiệm hiện đại cùng đội ngũ chuyên gia được đào tạo bài bản trong và ngoài nước. “Chúng tôi mong muốn tiếp tục hợp tác với các tổ chức, doanh nghiệp trong và ngoài nước để nghiên cứu, chuyển giao công nghệ và phát triển các giống nấm có giá trị kinh tế – dược liệu cao. Qua đó, góp phần thúc đẩy sản xuất nông nghiệp bền vững, mang lại lợi ích thiết thực cho cộng đồng,” ThS. Nguyễn Văn Trung chia sẻ.
Viện Nghiên cứu SHUD